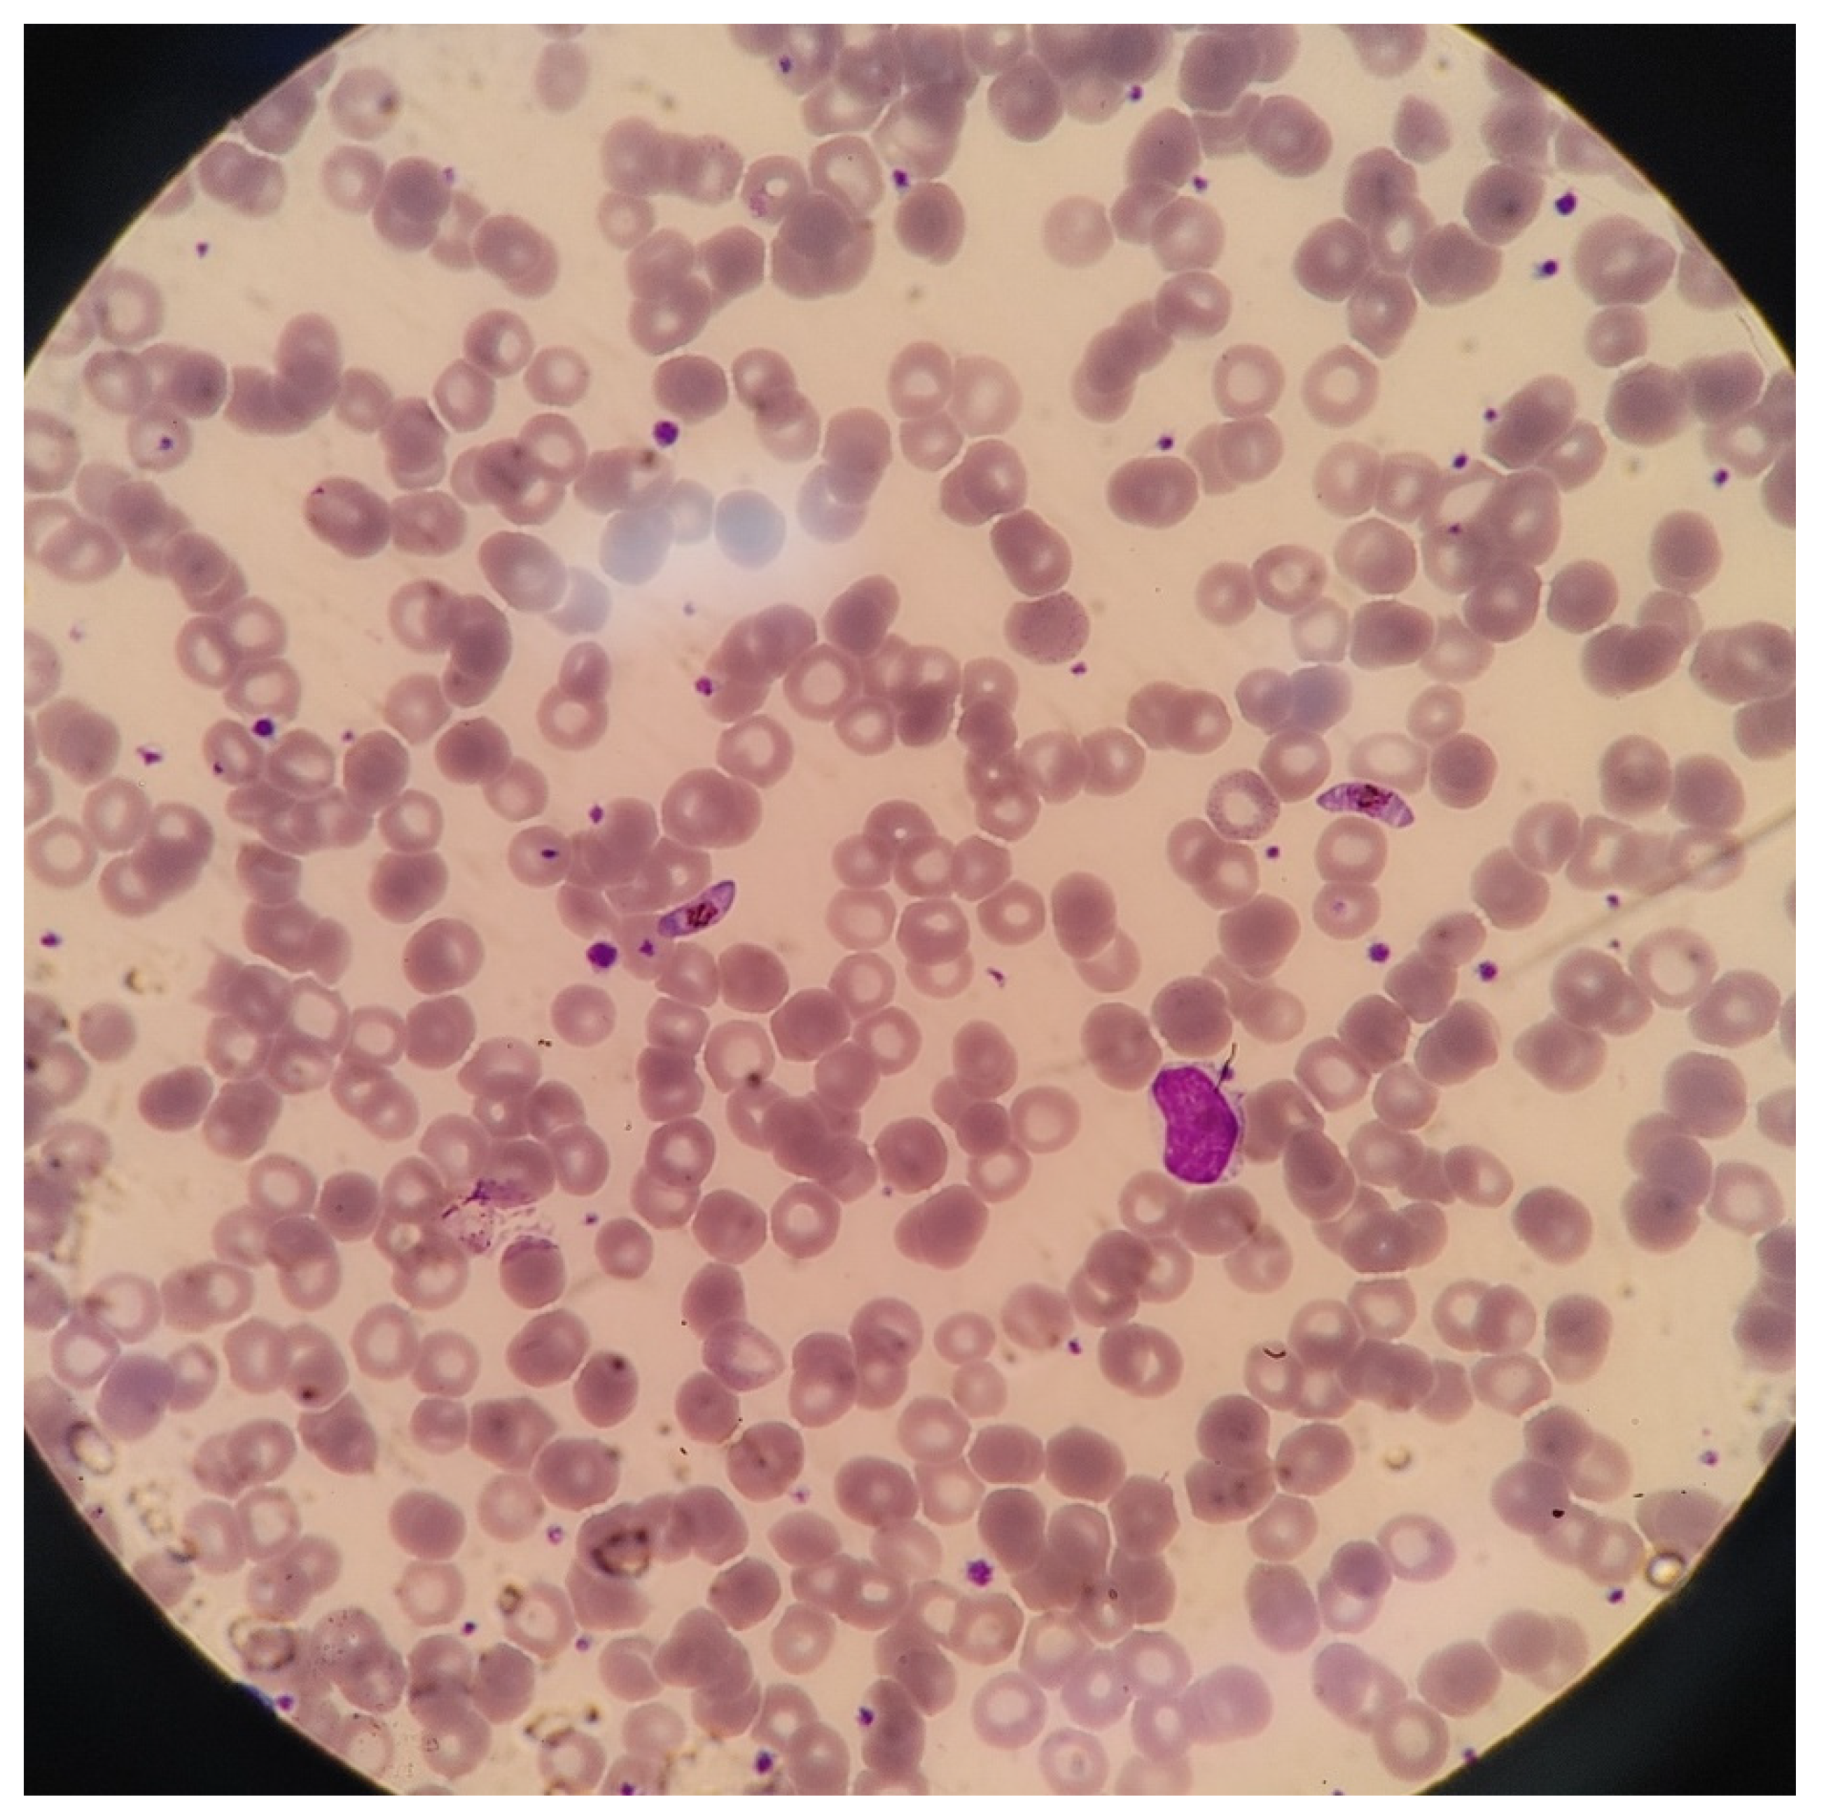

An Imported Case of Afebrile Plasmodium falciparum Malaria Infection from Tanzania in a Returning Traveler to the Republic of Korea following an Earlier COVID-19 Infection
Abstract
:1. Introduction
2. Case Report
3. Discussion
Author Contributions
Funding
Institutional Review Board Statement
Informed Consent Statement
Data Availability Statement
Acknowledgments
Conflicts of Interest
References
- Wilson, M.E.; Weld, L.H.; Boggild, A.; Keystone, J.S.; Kain, K.C.; von Sonnenburg, F.; Schwartz, E.; GeoSentinel Surveillance Network. Fever in returned travelers: Results from the GeoSentinel Surveillance Network. Clin. Infect. Dis. 2007, 44, 1560–1568. [Google Scholar] [CrossRef] [PubMed] [Green Version]
- Svenson, J.E.; MacLean, J.D.; Gyorkos, T.W.; Keystone, J. Imported malaria. Clinical presentation and examination of symptomatic travelers. Arch. Intern. Med. 1995, 155, 861–868. [Google Scholar] [CrossRef] [PubMed]
- Galatas, B.; Bassat, Q.; Mayor, A. Malaria Parasites in the Asymptomatic: Looking for the Hay in the Haystack. Trends Parasitol. 2016, 32, 296–308. [Google Scholar] [CrossRef] [PubMed] [Green Version]
- Im, J.H.; Kwon, H.Y.; Baek, J.; Park, S.W.; Durey, A.; Lee, K.H.; Chung, M.H.; Lee, J.S. Severe Plasmodium vivax infection in Korea. Malar. J. 2017, 16, 51. [Google Scholar] [CrossRef] [PubMed] [Green Version]
- Korean Centers for Disease Control and Prevention (KCDC). Malaria Management Guidelines (2015–2017); KCDC: Osong, Philippines, 2017.
- Iesa, M.A.M.; Osman, M.E.M.; Hassan, M.A.; Dirar, A.I.A.; Abuzeid, N.; Mancuso, J.J.; Pandey, R.; Mohammed, A.A.; Borad, M.J.; Babiker, H.M.; et al. SARS-CoV-2 and Plasmodium falciparum common immunodominant regions may explain low COVID-19 incidence in the malaria-endemic belt. New Microb. New Infect. 2020, 38, 100817. [Google Scholar] [CrossRef] [PubMed]
- Osei, S.A.; Biney, R.P.; Anning, A.S.; Nortey, L.N.; Ghartey-Kwansah, G. Low incidence of COVID-19 case severity and mortality in Africa; Could malaria co-infection provide the missing link? BMC Infect. Dis. 2022, 22, 78. [Google Scholar] [CrossRef] [PubMed]
- Ng, O.W.; Chia, A.; Tan, A.T.; Jadi, R.S.; Leong, H.N.; Bertoletti, A.; Tan, Y.J. Memory T cell responses targeting the SARS coronavirus persist up to 11 years post-infection. Vaccine 2016, 34, 2008–2014. [Google Scholar] [CrossRef] [PubMed]
- Takagi, A.; Matsui, M. Identification of HLA-A*02:01-restricted candidate epitopes derived from the non-structural polyprotein 1a of SARS-CoV-2 that may be natural targets of CD8+ T cell recognition in vivo. J. Virol. 2020, 95, e01837-20. [Google Scholar]
- Thomas, S. The Structure of the Membrane Protein of SARS-CoV-2 Resembles the Sugar Transporter SemiSWEET. Pathog. Immun. 2020, 5, 342–363. [Google Scholar] [CrossRef] [PubMed]
- Ou, X.; Liu, Y.; Lei, X.; Li, P.; Mi, D.; Ren, L.; Guo, L.; Guo, R.; Chen, T.; Hu, J.; et al. Characterization of spike glycoprotein of SARS-CoV-2 on virus entry and its immune cross-reactivity with SARS-CoV. Nat. Commun. 2020, 11, 1620. [Google Scholar] [CrossRef] [PubMed] [Green Version]
- Parodi, A.; Cozzani, E. Coronavirus disease 2019 (COVID 19) and Malaria: Have anti glycoprotein antibodies a role? Med. Hypotheses 2020, 143, 110036. [Google Scholar] [CrossRef] [PubMed]
- Yoshida, S.; Ono, C.; Hayashi, H.; Fukumoto, S.; Shiraishi, S.; Tomono, K.; Arase, H.; Matsuura, Y.; Nakagami, H. SARS-CoV-2-induced humoral immunity through B cell epitope analysis in COVID-19 infected individuals. Sci. Rep. 2021, 11, 5934. [Google Scholar] [CrossRef] [PubMed]
- Frasca, D.; Reidy, L.; Romero, M.; Diaz, A.; Cray, C.; Kahl, K.; Blomberg, B.B. The majority of SARS-CoV-2-specific antibodies in COVID-19 patients with obesity are autoimmune and not neutralizing. Int. J. Obes. 2022, 46, 427–432. [Google Scholar] [CrossRef] [PubMed]
- Gomes, L.R.; Martins, Y.C.; Ferreira-da-Cruz, M.F.; Daniel-Ribeiro, C.T. Autoimmunity, phospholipid-reacting antibodies and malaria immunity. Lupus 2014, 23, 1295–1298. [Google Scholar] [CrossRef] [PubMed]
Publisher’s Note: MDPI stays neutral with regard to jurisdictional claims in published maps and institutional affiliations. |
© 2022 by the authors. Licensee MDPI, Basel, Switzerland. This article is an open access article distributed under the terms and conditions of the Creative Commons Attribution (CC BY) license (https://creativecommons.org/licenses/by/4.0/).
Share and Cite
Lee, C.; Hong, S.K.; Kim, J.H. An Imported Case of Afebrile Plasmodium falciparum Malaria Infection from Tanzania in a Returning Traveler to the Republic of Korea following an Earlier COVID-19 Infection. Trop. Med. Infect. Dis. 2022, 7, 59. https://doi.org/10.3390/tropicalmed7040059
Lee C, Hong SK, Kim JH. An Imported Case of Afebrile Plasmodium falciparum Malaria Infection from Tanzania in a Returning Traveler to the Republic of Korea following an Earlier COVID-19 Infection. Tropical Medicine and Infectious Disease. 2022; 7(4):59. https://doi.org/10.3390/tropicalmed7040059
Chicago/Turabian StyleLee, Chaeryoung, Sung Kwan Hong, and Jong Hun Kim. 2022. "An Imported Case of Afebrile Plasmodium falciparum Malaria Infection from Tanzania in a Returning Traveler to the Republic of Korea following an Earlier COVID-19 Infection" Tropical Medicine and Infectious Disease 7, no. 4: 59. https://doi.org/10.3390/tropicalmed7040059
APA StyleLee, C., Hong, S. K., & Kim, J. H. (2022). An Imported Case of Afebrile Plasmodium falciparum Malaria Infection from Tanzania in a Returning Traveler to the Republic of Korea following an Earlier COVID-19 Infection. Tropical Medicine and Infectious Disease, 7(4), 59. https://doi.org/10.3390/tropicalmed7040059

